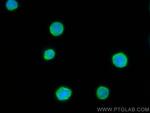
HLA-F Antibody in Immunocytochemistry (ICC/IF)

Search
Proteintech
HLA-F Monoclonal Antibody (1B12C2), CoraLite® Plus 488
{{$productOrderCtrl.translations['antibody.pdp.commerceCard.promotion.promotions']}}
{{$productOrderCtrl.translations['antibody.pdp.commerceCard.promotion.viewpromo']}}
{{$productOrderCtrl.translations['antibody.pdp.commerceCard.promotion.promocode']}}: {{promo.promoCode}} {{promo.promoTitle}} {{promo.promoDescription}}. {{$productOrderCtrl.translations['antibody.pdp.commerceCard.promotion.learnmore']}}
产品信息
CL488-66819
种属反应
宿主/亚型
分类
类型
克隆号
抗原
偶联物
激发/发射光谱
形式
浓度
规格
纯化类型
保存液
内含物
保存条件
运输条件
产品详细信息
Immunogen sequence: AGSHSLRYF STAVSRPGRG EPRYIAVEYV DDTQFLRFDS DAAIPRMEPR EPWVEQEGPQ YWEWTTGYAK ANAQTDRVAL RNLLRRYNQS EAGSHTLQGM NGCDMGPDGR LLRGYHQHAY DGKDYISLNE DLRSWTAADT VAQITQRFYE AEEYAEEFRT YLEGECLELL RRYLENGKET LQRADPPKAH VAHHPISDHE ATLRCWALGF YPAEITLTWQ RDGEEQTQDT ELVETRPAGD GTFQKWAAVV VPSGEEQRYT CHVQHEGLPQ PLILRWEQS
靶标信息
HLA-F belongs to the HLA class I heavy chain paralogues. It is a non-classical heavy chain that forms a heterodimer with a beta-2 microglobulin light chain, with the heavy chain anchored in the membrane. Unlike most other HLA heavy chains, this molecule is localized in the endoplasmic reticulum and Golgi apparatus, with a small amount present at the cell surface in some cell types. It contains a divergent peptide-binding groove, and is thought to bind a restricted subset of peptides for immune presentation.
HLA and MHC antibodies play a significant role in Immunopeptidomics, facilitating the identification and characterization of neoantigens through high-performance liquid chromatography coupled to tandem Mass Spectrometry.
仅用于科研。不用于诊断过程。未经明确授权不得转售。
篇参考文献 (0)
生物信息学
蛋白别名: CDA12; HLA class I histocompatibility antigen, alpha chain F; HLA F antigen; HLA-F; Leukocyte antigen F; MHC class I antigen F; non-classical; non-classical MHC class I antigen; nonclassical MHC class I antigen; unnamed protein product
基因别名: CDA12; HLA-5.4; HLA-CDA12; HLA-F; HLAF
UniProt ID: (Human) P30511
Entrez Gene ID: (Human) 3134